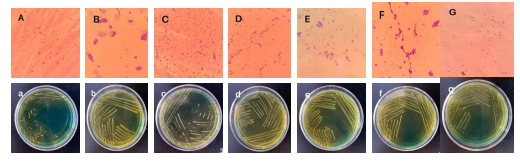

一、成果简介
酸菜是我国传统的发酵蔬菜制品,在自然发酵过程中受多因素影响而使品质难以稳定;东北酸菜腌制时间大多数在十月中旬,酸菜发酵启动慢易造成非发酵菌污染、发酵周期长和风味不稳定的问题。针对上述问题,本项目从北方较低地区筛选的清酒乳杆菌、植物乳杆菌和肠膜明串珠菌,进行组合制成酸菜发酵菌剂,采用接种发酵剂强化自然发酵的方法,提高酸菜品质。
二、预期市场分析
本成果可用在发酵蔬菜中,如酸菜和泡菜加工生产,可控制发酵蔬菜的质量和安全性,可提高中小型企业经济效益在1000万元以上。
三、拥有知识产权情况
无。
四、项目联系人
范洪臣
五、联系电话
0451-84844281
六、相关技术图片或成果样品图示